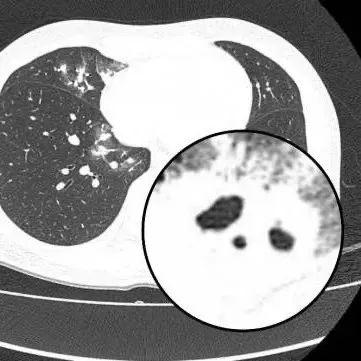

近日,30歲的夏女士(化名)
因持續乾咳一週到醫院就診
胸部CT顯示其雙肺多發感染
伴多發空洞形成
被收入呼吸與危重醫學科住院治療

醫生查房時,捕捉到CT上形似“鬼臉”的特殊影像(即“鬼臉徵”),並伴有“暈倫徵”,高度懷疑隱球菌肺炎。醫生追問夏女士近期是否曾接觸鳥類、禽類及飼養寵物,夏女士否認。

醫生安排夏女士抽血送檢,次日,血液及肺泡灌洗液均回報隱球菌抗原陽性,tNGS檢出高序列新型隱球菌,夏女士確診爲新型隱球菌肺炎。
得知這個診斷,夏女士回憶起來,兩週前她收到朋友送的兩隻鴿子,她把鴿子圈養在家四天,後續宰殺鴿子煲湯服用,這是確切的接觸史。醫生考慮感染新型隱球菌與宰殺鴿子相關。夏女士經過規範治療後,順利康復出院。
認識這個“僞裝大師”
隱球菌肺炎
醫生介紹,新型隱球菌是廣泛存在於鴿糞、土壤及腐爛植物中的真菌,乾燥後形成氣溶膠顆粒,通過呼吸道吸入感染人體。
高危人羣爲
養鴿人、鳥類愛好者、園藝工作者等
長期接觸鳥類或土壤者
及免疫力低下者
醫生表示,隱球菌肺炎初期可無症狀,輕症表現類似感冒(咳嗽、低熱、胸痛),易被忽視。
重症可能出現高熱、呼吸困難、咯血等症狀。若隱球菌肺炎未及時控制,約10%患者會併發腦膜炎,隱球菌腦膜炎死亡率高達60%-80%,若出現持續頭痛、噁心嘔吐,需立即就診。
如何明確診斷?
明確診斷通常通過血液檢查、肺泡灌洗液檢查或影像學檢查來診斷。其中乳膠凝集試驗也就是隱球菌抗原具有很高的特異性。
在免疫功能正常的患者中,肺部常見的表現爲單發或多發的結節,有時伴有暈徵(指結節周圍的低密度環),結節內可能見到空洞,胸膜下多見。在免疫功能缺陷(如惡性腫瘤、白血病等)的患者中,可能表現爲瀰漫的、大片的肺炎樣改變。
莫慌!治療有方需遵醫囑
實行抗真菌治療
醫生提醒,感染新型隱球菌,遵醫囑實行抗真菌治療。需密切門診隨診,足療程抗感染,切勿自行停藥。早診早治是關鍵,及時治療可完全吸收肺內病竈,避免後遺症。在預防方面,請注意:
養鳥人羣:
每日清理鳥籠(戴N95口罩+橡膠手套)。鳥籠放置通風處,避免臥室擺放。接觸後徹底洗手,衣物及時清洗。
高風險活動:
避免在鴿羣聚集處長時間停留,翻土種植時做好口鼻防護,不接觸野生禽類糞便。
健康監測:
若出現持續咳嗽、胸痛、發熱,尤其有鳥類接觸史者,需主動告知醫生,排查隱球菌感染。
來源:廣州日報、健康杭州







